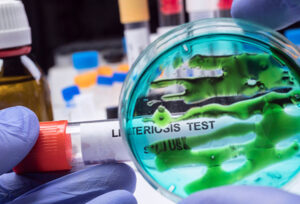
Suzanna’s Kitchen recalls almost 14,000 pounds of grilled chicken over LISTERIA risk – NaturalNews.com

Ancient astronaut theorists take note as scientists trace ancestral home of all humans to southern...
YouTube Video Here: https://www.youtube.com/embed/taungcjOHnk?feature=oembed&enablejsapi=1Mainstream scientists seem to have inadvertently given some support to the ancient astronaut theory again.Recently, we wrote...
Latest News
There are many companies selling AI products and they have invested over trillion dollars WITHOUT any return.The fact that they...
Research shows your body is exposed to over 80,000 known toxins every single day. From the air you breathe, the...
Brian Gerrish and Ben Rubin with today's UK Column News. 02:01 Farage: Nigel defends his trip to DavosUK’s Farage on Globalization...
Welcome to The Daily Wrap Up, an in-depth investigatory show dedicated to bringing you the most relevant independent news, as...
In this final episode, Abi reflects on her career and some of the obstacles she has overcome. Source link
Thank God for Scientific American! Those eggheads have finally done it! They’ve discovered a life-saving health tip, and they published...
News: Ancient Mysteries
YouTube Video Here: https://www.youtube.com/embed/2qiZpndjg6Y?feature=oembed&enablejsapi=1When we examine the ancient texts of Mesopotamia and Sumer, we are talking about the location of...
YouTube Video Here: https://www.youtube.com/embed/SfW4ULXtRFk?feature=oembed&enablejsapi=1Though they were first discovered in a Scottish cave in 1836 by local schoolchildren, they remain a...
More reports than ever before are constantly being filed from people claiming to have seen Unidentified Flying Objects, while alien...
YouTube Video Here: https://www.youtube.com/embed/AJLxyp5PDeU?feature=oembed&enablejsapi=1One of the main tenets of the ancient astronaut theory is that ancient beings may have manipulated...
YouTube Video Here: https://www.youtube.com/embed/S2UU1ozBmm0?feature=oembed&enablejsapi=1Everyone even remotely interested in extraterrestrials is searching for definitive proof, something tangible and real. So far,...
YouTube Video Here: https://www.youtube.com/embed/ru8ifph_q9o?feature=oembed&enablejsapi=1When “Lucy” the now-famous Australopithecine was discovered in Ethiopia in 1974 by paleoanthropologists, researcher’s minds were full...
News: UFO / Aliens
For decades, Linda Moulton Howe’s groundbreaking reports explored mysteries beneath Antarctica’s ice, alleging alien bases and ancient technology concealed deep...
“The Missing Diary of Admiral Richard E. Byrd” is a very short account of Byrd’s journey into “a paradise inside the...
Date of Sighting: March 31, 2007Time of Sighting: 8:30 to 9:00 AM AM PDTDuration of Sighting: 15 SecondsDate Sighting Reported:...
An unidentified object described as “a great red light in the sky” and “big as a battleship” has caused consternation...
We received a photo of an odd-shaped UFO in April 2024 from Erica Gregory who lives in Manchester, England. She...
“This is one of the strangest things I’ve seen on Mars,” says Jean Ward (L) who is a South African...
News: Health
YouTube Video Here: https://www.youtube.com/embed/lGH4MK9O2J0?feature=oembed&enablejsapi=1For decades, archaeologists have agreed that Homo sapiens were the first to create and use fire some...
YouTube Video Here: https://www.youtube.com/embed/taungcjOHnk?feature=oembed&enablejsapi=1Mainstream scientists seem to have inadvertently given some support to the ancient astronaut theory again.Recently, we wrote...
Suzanna’s Kitchen recalls almost 14,000 pounds of grilled chicken over LISTERIA risk
Suzanna's Kitchen is recalling about 13,720 pounds...
Trump administration pursues regime change in Cuba, citing Venezuelan success as blueprint
The Trump administration aims to collapse Cuba's...
“Wartime Homefront Essential Skills” on BrightU: How to navigate laws in collecting roadkill and how a common herbicide is...
YouTube Video Here: https://www.youtube.com/embed/U_REwdeweg4?feature=oembed&enablejsapi=1It’s one of the most well-known stories from the Bible: Noah and his family were instructed by...
News: Crypto
Ether (ETH) is flashing a familiar macroeconomic setup that preceded a major rally in 2021. One analyst highlighted a recurring...
Bitmine Immersion Technologies’ growing Ethereum staking position may translate into roughly $160 million in annual staking revenue at current rates,...
The bitcoin price steadied a bit today after an early slide to $86,000 over the weekend, as traders weighed Federal...
Gold advocate and longtime Bitcoin critic Peter Schiff renewed his attacks on Bitcoin during a recent interview with Tucker Carlson,...
Ripple has partnered with the innovation arm of Riyad Bank, a major Saudi financial institution, to explore the use of...
All of the bitcoin held by the U.S. government has come under scrutiny after allegations surfaced that tens of millions...
Video: News
Dave Rubin of “The Rubin Report” shares a DM clip of Border Patrol Chief Gregory Bovino refuses to take the...
Dave Rubin of “The Rubin Report” shares a DM clip of ABC News' David Muir caught pushing a fake narrative...
Dave Rubin of "The Rubin Report" talks about John Kennedy's appearance on "Real Time with Bill Maher" where he easily...
The Grayzone's Aaron Mate and Max Blumenthal explain how by initiating a generational conflict with Russia on the basis of...
The Grayzone's Max Blumenthal and Aaron Mate discuss the hypocrisy of French President Emmanuel Macron, who lectured the US on...
Video: Space
Take your personal data back with Incogni! Use code SPACEFLIGHT at the link below and get 60% off an annual...
In late September, when 3I Atlas' close approach with Mars was imminent, I asked for volunteers to search the Perseverance...
Artemis 2 is only two weeks away, and it has a heat shield problem. NASA has known this for years,...
As SpaceX closes in on completing the build of Pad 2, work has already begun on setting the stage for...
SpaceX just revealed that one of their satellites exploded in orbit! This is on top of the 300,000 collision avoidance...
Blue Origin unveils TeraWave, a bold new satellite megaconstellation promising terabit-class laser links, while also confirming ... source
Video: UFO / Aliens
Join this channel to get access to perks: https://www.youtube.com/channel/UCdXfEfd8eqyd4ZpRaxLwy3g/join Patreon: https://www.patreon.com/c/davidufomania Please subscribe: https://rumble.com/register/Ufomania/ ufomania-merch: https://teespring.com/ufomania-merch#pid=2&cid=2397&sid=front Follow us on TikTok:...
In today's podcast, Dr. Greer shares insights on his latest white paper entitled "How to Avoid Winning the Battle and...
Join this channel to get access to perks: https://www.youtube.com/channel/UCdXfEfd8eqyd4ZpRaxLwy3g/join Patreon: https://www.patreon.com/c/davidufomania Please subscribe: https://rumble.com/register/Ufomania/ ufomania-merch: https://teespring.com/ufomania-merch#pid=2&cid=2397&sid=front Follow us on TikTok:...
Join this channel to get access to perks: https://www.youtube.com/channel/UCdXfEfd8eqyd4ZpRaxLwy3g/join Patreon: https://www.patreon.com/c/davidufomania Please subscribe: https://rumble.com/register/Ufomania/ ufomania-merch: https://teespring.com/ufomania-merch#pid=2&cid=2397&sid=front Follow us on TikTok:...
Join David for an inspiring "pep talk" on how to maintain your spirituality and sanity in the midst of extreme...
The current understanding of unidentified aerial phenomena is being dismantled by this intriguing theory. Imagine a force that doesn't visit...
Video: Ancient Mysteries
Join this channel to get access to perks: https://www.youtube.com/channel/UCC9JHVPm-4P5QDp9vk8EH-A/join Patreon: www.patreon.com/MysteryHistory Follow us on Facebook: www.facebook.com/MysteryHistoryBook Donate via PayPal: mysteryhistory@ctemplar.com...
Join this channel to get access to perks: https://www.youtube.com/channel/UCC9JHVPm-4P5QDp9vk8EH-A/join Follow us on Facebook: www.facebook.com/MysteryHistoryBook TikTok: www.tiktok.com/@mysteryhistorytiktok Support us on Patreon:...
Giants, megaliths, and lost knowledge https://www.gaia.com/awakening collide as Hugh Newman explores ancient stone ... source
Tracking the storm thats suppose to bring lots of white stuff into the Mountains. Lets see whats going on. Wolf...
Tracking the storm thats suppose to bring lots of white stuff into the Mountains. Lets see whats going on. Wolf...
Video: Anomalies
*Please Watch to the End ** Watch in HD and Full Screen As always, look for the picture links at...
Grab a shirt: https://www.UAPmerch.com Follow me for news & fast video updates: • Instagram: https://www.instagram.com/secureteamtyler/ • X: https://x.com/SecureTeam10 • Facebook:...
Video: Spirituality
📚 Feel Alive II - Unlock Your Infinite Power By Ralph Smart: https://ralphsmart.com/thebook/ Get The New Book | Now Available...
Ramana Maharshi dismantles the ideas of soul and reincarnation at their root.* In this uncompromising talk, we enter the heart...
📚 Feel Alive II - Unlock Your Infinite Power By Ralph Smart: https://ralphsmart.com/thebook/ Get The New Book | Now Available...
Video: Philosophy
Go to http://polymarket.com to trade on the outcomes of live events from politics, pop culture, to sports and more! Hollywood...
It's common for people feel a cabal or Deep State controls the entirety of the world. Is this accurate? Or...
Watch the full interview: https://youtu.be/Xx351NmhCEk Yanis Varoufakis is an economist, the former Finance Minister of Greece, and the author of...
Shop the Closer To Truth merch store for items like hoodies, T-shirts, mugs, and more: https://bit.ly/3P2ogje Dr. Imants Barušs is...
Trust in worldly institutions is shattered. source
Video: Health
FREE Guide 'The Happiness Prescription: 5 Daily Rituals That Rewire Your Brain for Joy' HERE: ... source
PURCHASE ON GOOGLE PLAY BOOKS ▻▻ https://g.co/booksYT/AQAAAEAaAgRCDM The Spontaneous Evolution Experience: ... source
Watch the full episode with Bruce Lipton here: https://youtu.be/tBqlskhcyR8. source
This episode is brought to you by: VIVOBAREFOOT: Get 20% off your first order https://links.drchatterjee.com/4nqvRI3 THE WAY ... source
Swadhyaya Session on “BIOLOGY OF BELIEF” by Bruce H. Lipton Welcome to our BEHF India Swadhyaya Session from Training ......
Video: Entertainment
During their New Year New You event, get up to 35 percent OFF select Magnesium Breakthrough ritual bundles and 26...
Become a Premium Member: https://www.jimmydore.com/premium-membership Go to a Live Show: ... source
Candace Owens has a LOT of questions surrounding Charlie Kirk's assassination and the operations at TPUSA. But the one key...
Everyone knows that mega-wealthy donors, particularly pro-Israel billionaires, exert major influence over U.S. politicians through ... source
Recent reports suggest that China has rapidly increased military support to Iran, with multiple Chinese cargo planes landing in ......
During a recent live stream, Candace Owens alleged that her former friend and fellow online commentator Dave Rubin acted ......
Free Nation
- USD
- EUR
- GBP
- AUD
- JPY
Bitcoin(BTC)
$88,426.00Ethereum(ETH)
$2,936.21Tether(USDT)
$1.00BNB(BNB)
$883.55XRP(XRP)
$1.90USDC(USDC)
$1.00Solana(SOL)
$124.22TRON(TRX)
$0.295408 Lido Staked Ether(STETH)$2,935.19
Lido Staked Ether(STETH)$2,935.19Dogecoin(DOGE)
$0.122513
Categories
- News: Ancient Mysteries (170)
- News: Crypto (5,486)
- News: Health (3,011)
- News: Latest News (2,872)
- News: UFO / Aliens (352)
- Video: Ancient Mysteries (2,065)
- Video: Anomalies (2,013)
- Video: Entertainment (3,207)
- Video: Health (3,024)
- Video: News (3,917)
- Video: Philosophy (6,982)
- Video: Space (2,777)
- Video: Spirituality (4,267)
- Video: UFO / Aliens (3,734)
Archives
- January 2026 (1548)
- December 2025 (2102)
- November 2025 (2055)
- October 2025 (2151)
- September 2025 (2141)
- August 2025 (2081)
- July 2025 (2268)
- June 2025 (2214)
- May 2025 (2070)
- April 2025 (1765)
- March 2025 (1002)
- February 2025 (563)
- January 2025 (535)
- December 2024 (486)
- November 2024 (480)
- October 2024 (404)
- September 2024 (374)
- August 2024 (403)
- July 2024 (329)
- June 2024 (336)
- May 2024 (270)
- April 2024 (314)
- March 2024 (339)
- February 2024 (297)
- January 2024 (269)
- December 2023 (307)
- November 2023 (263)
- October 2023 (249)
- September 2023 (230)
- August 2023 (263)
- July 2023 (269)
- June 2023 (290)
- May 2023 (317)
- April 2023 (322)
- March 2023 (351)
- February 2023 (322)
- January 2023 (302)
- December 2022 (257)
- November 2022 (259)
- October 2022 (247)
- September 2022 (214)
- August 2022 (237)
- July 2022 (260)
- June 2022 (214)
- May 2022 (239)
- April 2022 (1570)
- March 2022 (2392)
- February 2022 (2558)
- January 2022 (2866)
- December 2021 (1515)
- November 2021 (184)
- October 2021 (51)
- September 2021 (274)
- August 2021 (4)
- July 2021 (19)
- June 2021 (114)
- May 2021 (80)
- April 2021 (42)